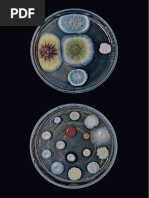

Dioses Sumerios [Link]
htm
Home/Reset
Historia
Informes
Algunos DIOSES
Mapas
Galeria de Fotos
Utilidades
Los sumerios tenian numerosos dioses a los que invocaban su protección.
Existía una trinidad de dioses mayores (Enlil, Enki,Ea ).
Tambien existian dioses y diosas patronos o protectores de una determinada ciudad
(Ningirsu en Lagash, Shara en Umma).
Algunos reyes tambien tenian sus dioses protectores (Ningishzidda y Lama - Gudea).
Los acadios adoptaron estas mismas deidades, cambiando sus nombres.
La tradicción semita, hebrea y posteriores tienen sus bases en la mitología sumeria:
La creación del Universo. Nammu creó el cielo y la tierra (que se la dió a Ki y a An), Su hijo
Enlil, creó la atmósfera, el viento , la tormenta y separó el día de la noche. Enlil con Ki crearon los
animales, y las plantas. Los hombres fueron creados por Enki y Ki para servir los dioses.
La mujer (Eva). Ki creó con la costilla de Enki una diosa, Nin-ti, que significa mujer de la costilla
El [Link] creó un lugar donde el hombre podía vivir sin miedo a los animales (serpientes,
hienas, escorpiones o leones) un lugar sin terror, pero Enki descubrió un comportamiento
inadecuado en los humanos y los expulsó.
Caín y Abel. Dos dioses, Emesh (el verano) y Enter (el invierno), que inicialmente fueron
encargados por Enlil para que uno se encargara de las cosechas y la agricultura y otro de los
animales y el ganado, pero que tuvieron una gran disputa.
Un problema parecido huvo enter Ashnan (diosa del grano) y Lahar (diosa del ganado). Después
de un aborrachera estuvieron peleando y Enlili y Enki tuvieron que mediar.
El [Link] 7 días y 7 noches llovió sin parar pero Ziusudra, avisado por el dios Utu
(Shamash), creó un barco, donde guardó ejemplares de semillas y animales. Cuando dejó de
llover, y apareció el sol, Ziusudra (Utnapishtin) hizo el sacrificio de una oveja al dios Utu.
Es lógico pensar que Abraham, cuando huyó de Ur, al final de la III Dinastía por causa de la
invasión amorrea, se basase en esta tradición cuando creó la religión hebrea.
DIOSES MAYORES. Primera Tríada.
An (Anu) El rey de los dioses, cabeza de familia. Dios del paraiso y de la tierra. Dios del firmamento
estrellado, el espíritu monarca de la esfera superior. Su simbolo era una estrella. De acuerdo con la tradición
sumeria, vivía en el Paraiso y hacía visitas a la tierra en épocas de crisis o en [Link] en Uruk
llamado [Link] (la casa de AN). De su unión con Nannu tuvo a Enki, y de su unión con Ki tuvo a Enlil.
Relacionado con el dios asirio Asur o el dios filisteo Dagon. Se representa con un disco alado, que emerge de
un busto humano con una taira real, doblecornamenta y cola de aguila, en el acto de tensar un arco para
lanzar una flecha. Sus hijos y seguidores fueron los Anunnaki o Annuna..
Enlil Dios mas importante de los sumerios. Hijo de An (El paraiso) y de la diosa Ki (la tierra). Señor del
"lil". Padre de los dioses y de los hombres. Reina sobre la atmosfera, el aire, las tormentas, el viento. Dios de
la fuerza y de la violencia. Llegó a la tierra antes de la llegada de los hombres, separó el paraiso de la tierra.
En El Paraiso se situa detrás de su padre, y en la tierra cuando se reunen lo dioses, lo hacen en su templo
Ekur en Nippur. Nippur era la ciudad Sagrada, solo habitada por sacerdotes. De su unión con la diosa Ninlil
tuvo su hija Sin. Padre de Ningirsu.
1 de 4 07/05/2014 14:37
�Dioses Sumerios [Link]
Enki (Ea) Dios sumerio de las Aguas, la fertilidad y de la sabiduria. Surge del caos húmedo, de las aguas
marinas, e impregna a la Tierra y da vida a los seres que la pueblan. Protector de marinos y navegantes.
Llamado Ea por los acadios. El Guardián de las leyes divinas y del ME (el orden sin el caos, el gran atributo de
la civilizacion el poder de los dioses). Su ciudad era Eridu. Innana le convenció (engaño?) para que le cediera
algunas de sus responsabilidades. Se le representa a menudo como un ser con cuerpo de pez del que surge
una cabeza humana y con pies similares a los humanos.
Otros DIOSES
Adab Dios del trueno y de la tormenta
Alla Dios menor. Mensajero de Ningishzidda
Antu Madre de Anu
Anunitu Dios acadio.
Baba Diosa protectora de Lagash. Templo en Lagash
Dagan(Dagon) Dios de Tutul en Balikh. Ciudad conquistada por Sargón. Este dios fue incorporado al
panteón sumerio acadio
Dumuzi o Dumuzz. Consorte de Inanna. Dios de la vegetación.
Ereshkigal Hermana oscura de Enki. Diosa del mundo subterraneo, la oscuridad, la [Link] de
Inanna.
Geshtinnana Dios menor
Gugalamma Marido de Ereshkingal. "Toro del Cielo"
Inanna (Innin) Diosa. Templo en Zabalam. Protectora de Uruk (Erech). Asociada con la estrella
matutina (Venus).Diosa del amor y de la guerra. Era la diosa de la naturaleza y de la fecundidad,
prolongación de la tradición de "diosas madres" , fue la protagonista de mitos tan arquetípicos como el del
"descenso a los infiernos". Se la identificaba con la diosa griega Afrodita y la Astarté fenicia. En algunas
tradiciones es hija de Anu y Ki (la tierra), y en otras de Sim y Ningal (la luna). Tiene 7 templos en Summer.
Aunque el mayor estaba en Uruk [Link]. Su consorte fue Dumuzz (Semidios y heroe de Uruk)i. El templo de
Eanna en Uruk, está dedicado a ella y a Anu.
Ishtar Diosa acadia equivalente a Inanna. Reina del amor y de la guerra.
Ki Diosa de la tierra, madre de Enlil. A menudo se le confunde con Ninhursag (reina de las montalas),
Ninmah (la señora exaltada) o Nintu. Participó con Enlil y con Enki en la creación del mundo y de loshombres.
Algunos la consideran parte de la primera triada como un dios mayor,
Lama Diosa personal de Gudea
Nanna o Nannar o Zuen Otro nombre de la dios de la luna Sin.
Nannu o Nammu Diosa inicial del mundo, existia desde el inicio. Diosa de las profundidaes marinas.
Ella creó el cielo y la tierra. Madre de los dioses , como Enki . Mujer de An
Nanshe Diosa protectora de Lagash.
Nergal o Menslamtaea. Dios de mundo subterraneo. Segundo Hijo de Enlil y Ninlil .
Nidaval o Nisaba o Nasaba. Diosa de la [Link] de los cereales. Protectora de archivos
reales. Diosa protectora de Umma.
Ninazu. Dios hijo de Ninlil y Enlil en el mundo oculto. Permanece alli, pues Ninlil no se pudo traer
Ningal Diosa de la luna. (Protectora de Ur)
Ningirsu Dios sumerio, protector de Lagash (dios de Girsu). Es un dios guerrero y eliminador de
demonios. Dios del huracá[Link] templo construido por Ur-Nause, rey de Lagash, en Tello, fue destruido por
Lugalzagesi, rey de Umma, y posteriormente reconstruido por Gudea (epoca neosumeria). Se le asocia a
Ninurta.
Ningishzida Dios sumerio de la vegetación. Dios personal de Gudea
Nin-Gizzida Dios del inframundo
Ninkasi Diosa de la bebida. Hija de Ninhursag y Enki. (1 de sus 8 hijos).
Ninhursag o Ninkhursag Hija de Anu. A veces se confunde con Ki. Fue amante de Enki, diosa de
la medicina y de la naturaleza. Siguiendo los consejos de Enki creó al hombre. Se le llamaba "Mammu"
2 de 4 07/05/2014 14:37
�Dioses Sumerios [Link]
(madre, mama). Tuvo un hjo con Enlil que se llamo NINURTA (el señor de la fuente). Templo en El Obeid.
Ninisinna Diosa protectora de Isin
Ninki Diosa esposa de Enki
Ninlil Diosa esposa de Enlil. Madre de Sim. Protectora de Tummal, distrito de Nippur.
Ninmakh o Ninmah La señora de la montaña, de carácter agrícola. Equivale a Ninshursag
Ninurta Hijo de Enlil y Ninhursag, titular de la vegetación y de la caza. Señor del arado.
Shara Diosa sumeria, protectora de Umma.
Sin Dios sumerio de la luna. Hijo de Enlil y Ninlil, nació en el mundo subterraneo y fue obligado a
permanecer durante su infancia en el mundo de la muerte. Deidad tutelar de Ur. Es el dios de la noche,
representado a veces como un toro; rige los movimientos de la noche y del día y las fases de la luna. Otras
veces se le representa como el disco lunar, o con forma de hombre mitrado. Sim se caso con Ningal (diosa de
la luna) y tuvieron como hijos Inana y Utu
Utu (Shamash) Hijo de Sim y Ningal. Dios sumerio del sol y de la justicia y de los oráculos. Llamado
Shamash por los acadios. Dios solar que surge por el Este en su carro de oro y que recorre el firmamento en
torno al mundo entero, y que finalmente se va por Occidente y se recoge en su morada Ebabbarra (en las
produndidades) al finalizar cada dia. Protegía a todos los seres creados de la oscuridad y de las potencias del
mal que acechan en ella. Era tenido por el rey de la "magia blanca". Era patrón de las leyes y de la justicia,
bueno y justo.
Tabla de relación entre los dioses
F Ir al inicio de la página
E Volver a la página anterior
E Recargar la página principal
Modificado el 03/09/2010 [Link]
3 de 4 07/05/2014 14:37
�Dioses Sumerios [Link]
Copyright © 2001-114 Julio Bou. All rights Reserved.
Permitida su reproducción total o parcial siempre que se mencione el origen
4 de 4 07/05/2014 14:37